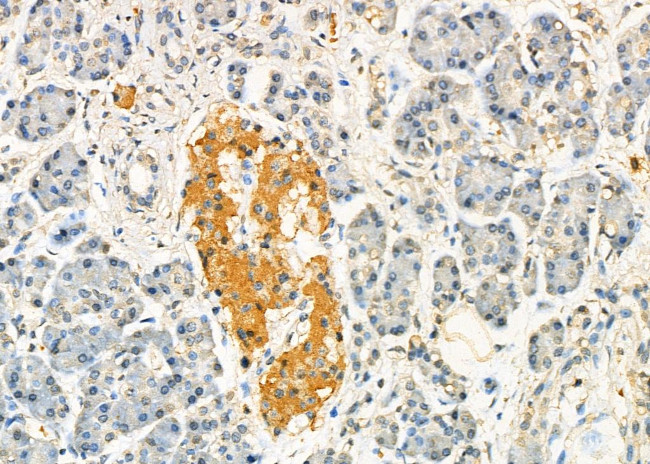
PEO1 Antibody in Immunohistochemistry (Paraffin) (IHC (P))

Search
Invitrogen
PEO1 Polyclonal Antibody
{{$productOrderCtrl.translations['antibody.pdp.commerceCard.promotion.promotions']}}
{{$productOrderCtrl.translations['antibody.pdp.commerceCard.promotion.viewpromo']}}
{{$productOrderCtrl.translations['antibody.pdp.commerceCard.promotion.promocode']}}: {{promo.promoCode}} {{promo.promoTitle}} {{promo.promoDescription}}. {{$productOrderCtrl.translations['antibody.pdp.commerceCard.promotion.learnmore']}}
图: 1 / 2
PEO1 Antibody (PA5-102720) in IHC (P)


Please note: We are reviewing Western blot images included in the antibody testing data in our catalog, including those provided by third parties. Unless expressly labeled or annotated as “raw-unedited”, Western blot images included in the antibody testing data in our catalog may have been edited, optimized or otherwise adjusted for presentation.
产品信息
PA5-102720
种属反应
宿主/亚型
分类
类型
抗原
偶联物
形式
浓度
规格
纯化类型
保存液
内含物
保存条件
运输条件
RRID
产品详细信息
Antibody detects endogenous levels of total C10orf2.
靶标信息
Twinkle is a mitochondrial protein with structural similarity to the phage T7 primase/helicase (GP4) and other hexameric ring helicases. The twinkle protein colocalizes with mtDNA in mitochondrial nucleoids, and its name derives from the unusual localization pattern reminiscent of twinkling stars.Twinkle is a mitochondrial protein with structural similarity to the phage T7 primase/helicase (GP4) and other hexameric ring helicases. The twinkle protein colocalizes with mtDNA in mitochondrial nucleoids, and its name derives from the unusual localization pattern reminiscent of twinkling stars (Spelbrink et al., 2001 [PubMed 11431692]).[supplied by OMIM]. Publication Note: This RefSeq record includes a subset of the publications that are available for this gene. Please see the Entrez Gene record to access additional publications.
仅用于科研。不用于诊断过程。未经明确授权不得转售。
篇参考文献 (0)
生物信息学
蛋白别名: Ataxin8; ATXN 8; C10 orf2; C10orf 2; FLJ21832; PEO 1; progressive external ophthalmoplegia 1 homolog; Progressive external ophthalmoplegia 1 protein; Progressive external ophthalmoplegia 1 protein homolog; SCA 8; T7 gp4-like protein with intramitochondrial nucleoid localization; T7-like mitochondrial DNA helicase; Twinkle mtDNA helicase; Twinkle protein, mitochondrial
基因别名: C10orf2; D19Ertd626e; PEO; PEO1; Twinl; TWNK
UniProt ID: (Mouse) Q8CIW5
Entrez Gene ID: (Mouse) 226153, (Rat) 309441